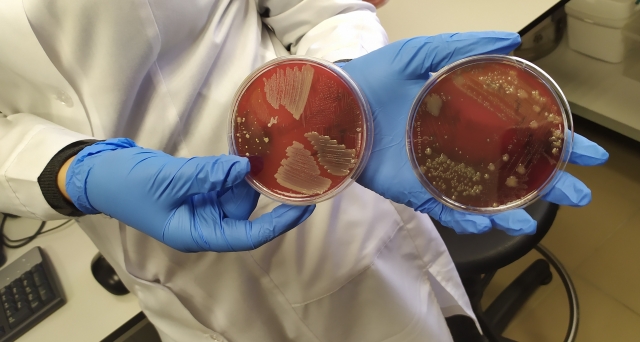

МИ ЖИВЕМО У СВІТІ БЕЗМЕЖНИХ ТЕХНОЛОГІЧНИХ МОЖЛИВОСТЕЙ!
У сучасному світі, щоб бути конкурентним спеціаліст з тваринництва має користуватися сучасними досягненнями науки та техніки в своїй роботі та бути обізнаним у сфері передових технологій світової лабораторно-дослідницької практики.
Завдяки зусиллям завідувача кафедри годівлі тварин та технології кормів ім. П.Д. Пшеничного Сичова Михайла Юрійовича науково-педагогічні працівники факультету тваринництва та водних біоресурсів з ним на чолі ознайомилися та поглибили свої знання в сфері фізико-хімічного аналізу на базі ТОВ Експертний центр діагностики та лабораторного супроводу «Biolights».


З новітніми методиками лабораторних досліджень викладачів НУБіП України ознайомили Генеральний директор експертного центру «Biolights» Мартиненко Ольга та експерт з питань якості та безпеки кормів Рубан Наталія. Слід зазначити, що це єдиний в Україні інноваційний, незалежний лабораторний комплекс європейського рівня по дослідженню харчових продуктів, кормів, води, та ветеринарної діагностики.

Високотехнологічне обладнання лабораторії дозволяє проводити біля тисячі найскладніших лабораторних досліджень за всіма напрямками харчової, ветеринарної та сільськогосподарської діяльності. Експертний центр «Біолайтс» із гордістю представив перший в Україні, автоматичний бактеріологічний аналізатор – MALDI-TOF (Bruker, США). Застосування мас-спектрометрії в мікробіології – інноваційний в Україні підхід до діагностики бактеріальних захворювань та ідентифікації будь-яких мікроорганізмів.
Технологія MALDI – базується на роботі лазеру, що пронизує біологічний субстрат, культуру бактерій або грибків, підіймаючи у вакуум специфічні білки і надаючи їм певного заряду. Як детектор використовується мас-спектрометр ToF, який аналізує спектр білків, для порівняння з базою даних мікроорганізмів, та видає точний результат. Його точність прирівнюється до секвенування генів, а швидкість та вартість аналізу є головною перевагою. Прилад дозволяє ідентифікувати майже всі відомі на сьогодні мікроорганізми. База даних нараховує майже 7000 штамів мікроорганізмів.

Сучасна електронна система управління лабораторною інформацією LIMS дозволяє вести документацію клієнтської бази як в Україні та і за її межами.

Швидкі та точні результати отримують в лабораторії під час дослідження крові тварин. Вони виконується із застосуванням імуно-ферментного аналізу та постановки реакції затримки гемаглютації, що ґрунтується на реакції «антиген-антитіло», це дозволяє виявляти речовини білкової природи (ферменти, бактеріальні фрагменти, віруси тощо).

Під час зустрічі спеціалісти лабораторії поділилися своїм досвідом у сфері фізико-хімічних досліджень м’яса, кормів, кормової сировини та води.

Аналітичні дослідження зразків методами атомної адсорбції, рідинної та газової хроматографії проводяться з метою визначити кількість пестицидів, важких металів та інших показників безпеки. Також вони дозволяють встановити наявність вітамінів, амінокислот та інших показників якості в досліджуваних матеріалах.


Викладачі кафедри годівлі тварин та технології кормів ім. П.Д. Пшеничного висловлюють щиру вдячність директору експертного центру діагностики та лабораторного супроводу «BioLightS» Ользі Анатоліївні, експерту з питань якості і безпеки кормів – Наталію Рубан та фахівцям центру за безцінні поради та отримані під час візиту нові знання в галузі лабораторних досліджень.
Асистент кафедри годівлі тварин та
технології кормів ім. П.Д. Пшеничного
Андрієнко Любов Миколаївна